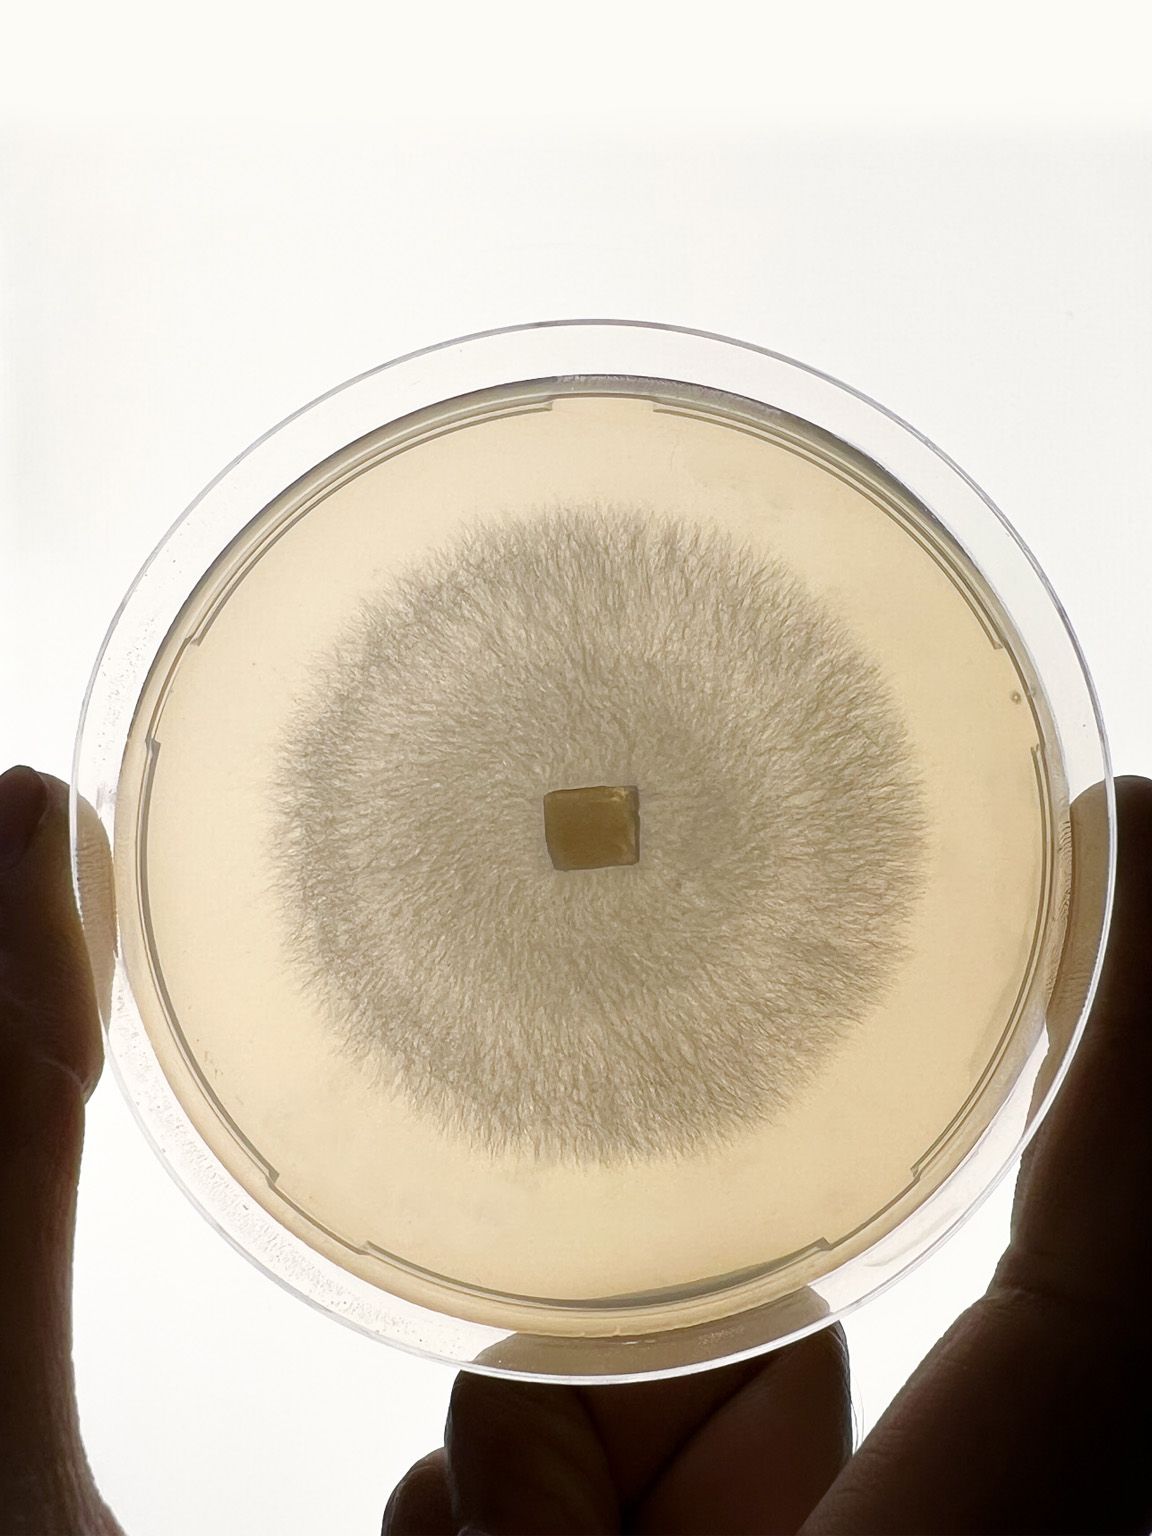

Research + Innovation
We believe architecture is strengthened by research that draws in perspectives beyond its traditional boundaries.
Approach
We investigate emerging ideas through interdisciplinary collaboration, cultural inquiry and material exploration. In doing so, we generate insight that expands how architecture is understood and imagined.
Services
Collaborative
Our work is developed with academics, social scientists, activists, designers, philosophers and industry thinkers. We seek out unexpected partnerships and shared inquiry, building connections that challenge assumptions and open new lines of thought. Collaboration allows us to move beyond the limits of a single discipline and close the gap between practice and emerging ideas.
Experimental
We pursue novelty with intent. From engineered timber towers to mycelium composites, from wearable technologies to adaptive housing systems, we explore new materials, systems and spatial possibilities. We pride ourselves on never doing the same thing twice, using experimentation as a way to rethink how architecture relates to health, culture, ecology and everyday life.
Speculative
We ask probing questions about the forces reshaping cities and buildings. How might mobility evolve? How does neurodiversity change the workplace? Can culture be embedded at the start of development? By examining possible futures and shifts in society, technology and climate, we expand the boundaries of architectural thinking and share insight with the wider industry.

We believe our responsibility is to enhance the quality of built life on this planet. Through research, dialogue and regenerative thinking, PLP Labs explores what is coming next and what architecture might become.
Research Collaborators
Michael Ramage
Professor, University of Cambridge, CNMI
Joyce Chan-Schoof
Head of Programme Requirements, UK Parliament
Rhael 'LionHeart' Cape Hon FRIBA
Multi-Disciplinary Artist and Poet
Ana Gatóo
Lecturer in Regenerative Design
Merlin Sheldrake
Mycologist and Author
Glenn Albrecht
Eco Philosopher and Author
Urban Land Institute
Global Non-profit
Centric Lab
Non-profit Research Lab
Dromos GmbH
Autonomous Network Transit








